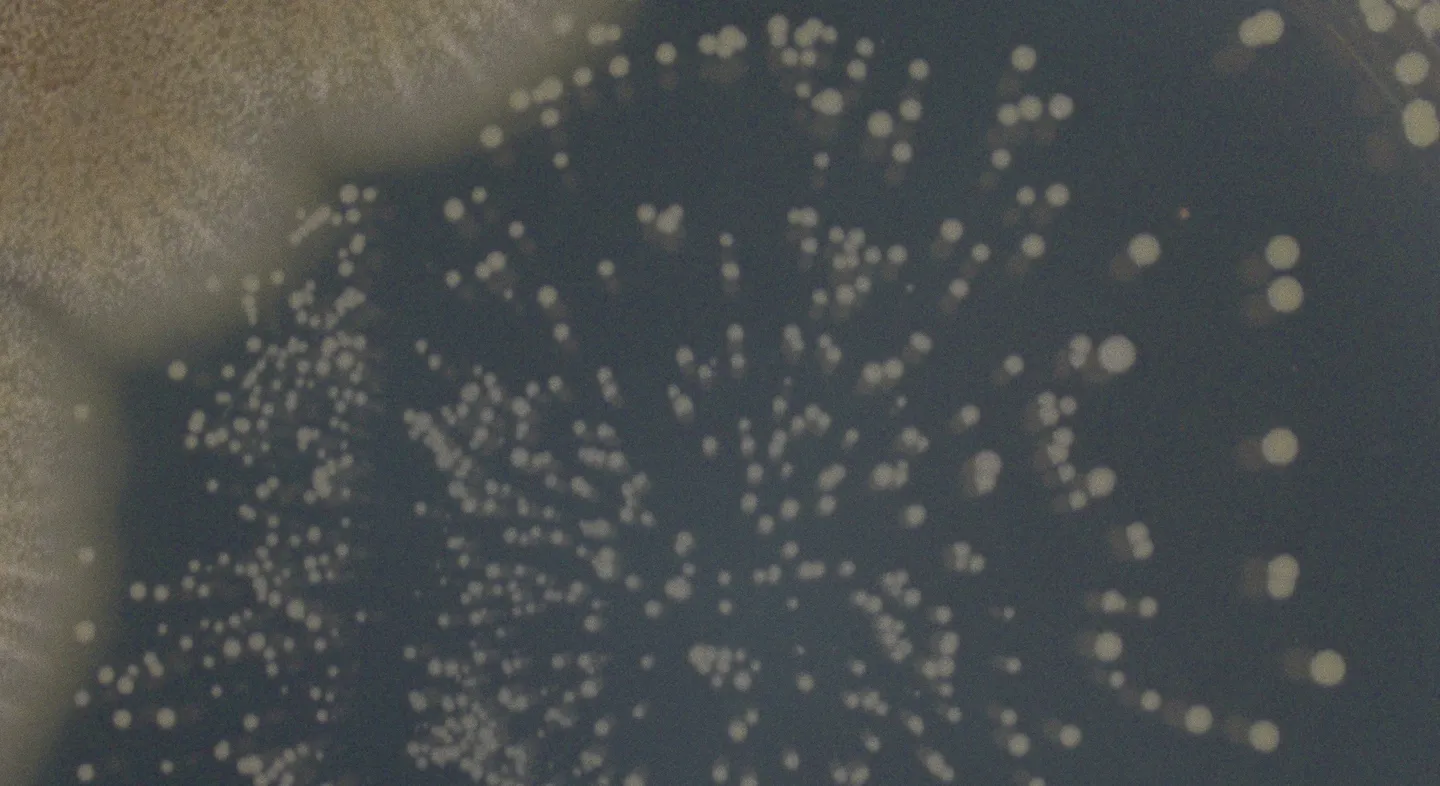
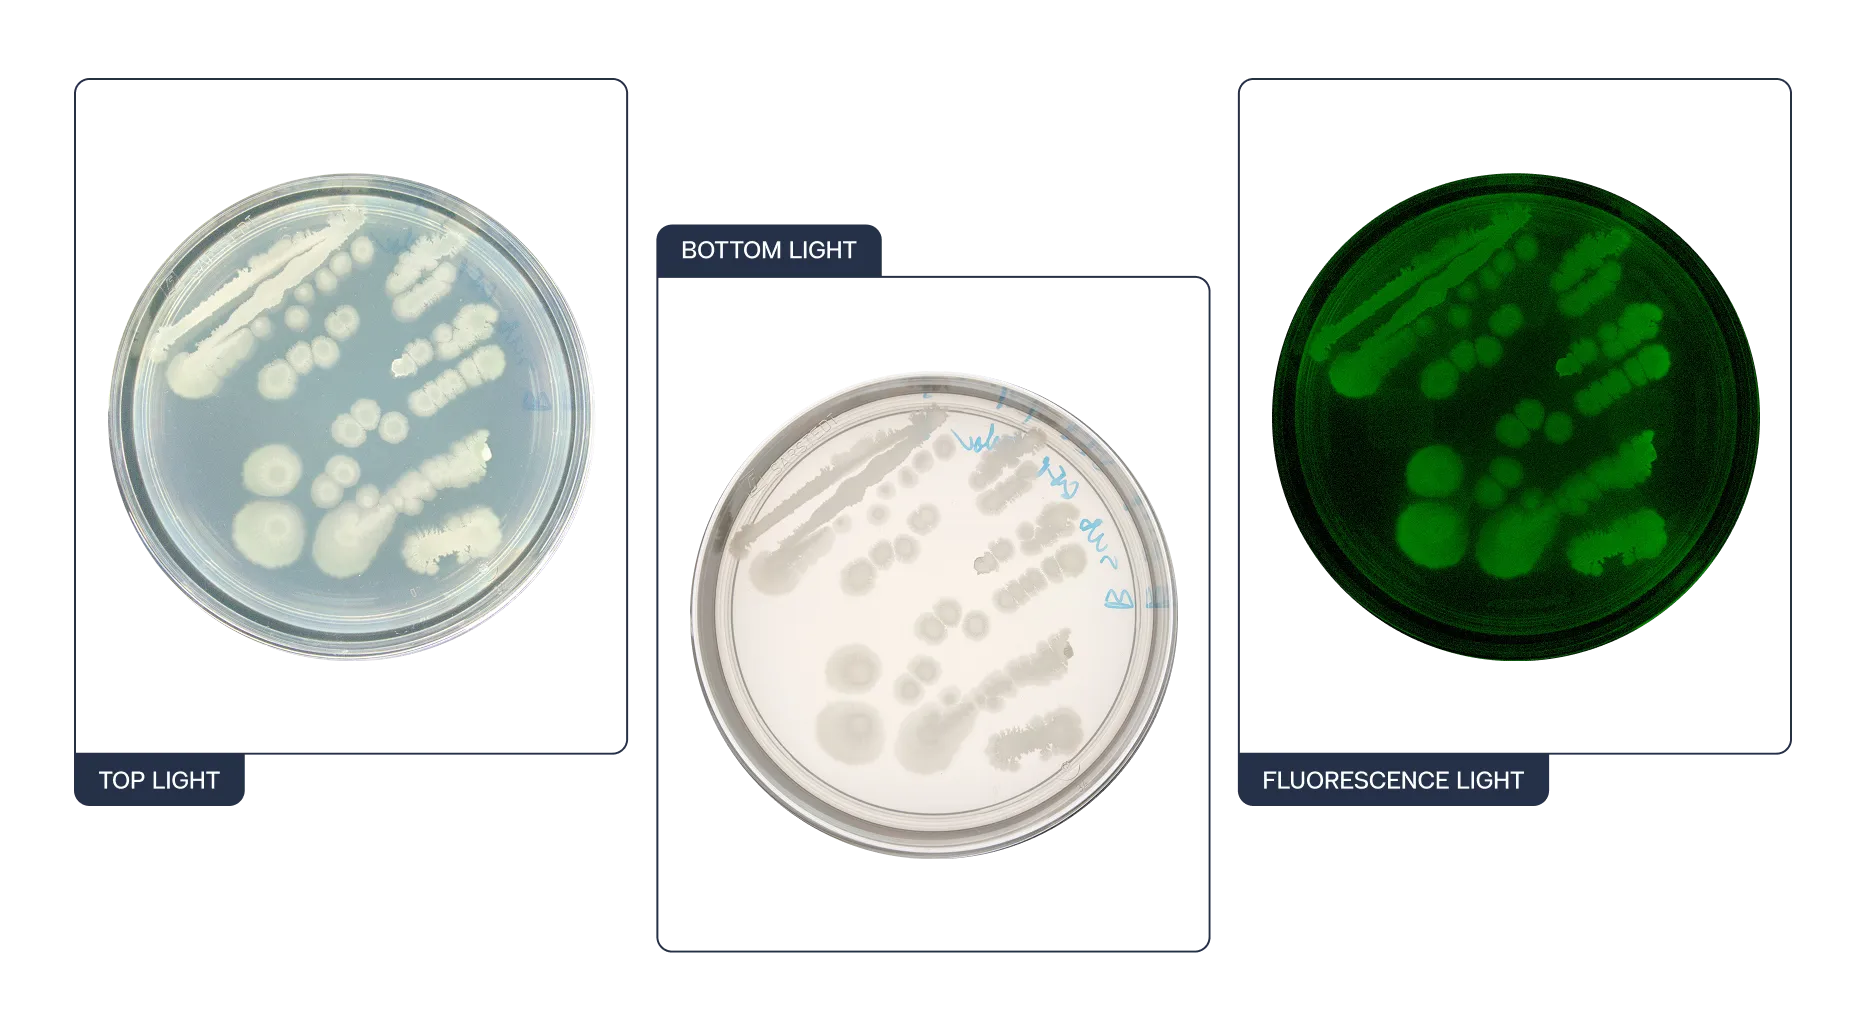
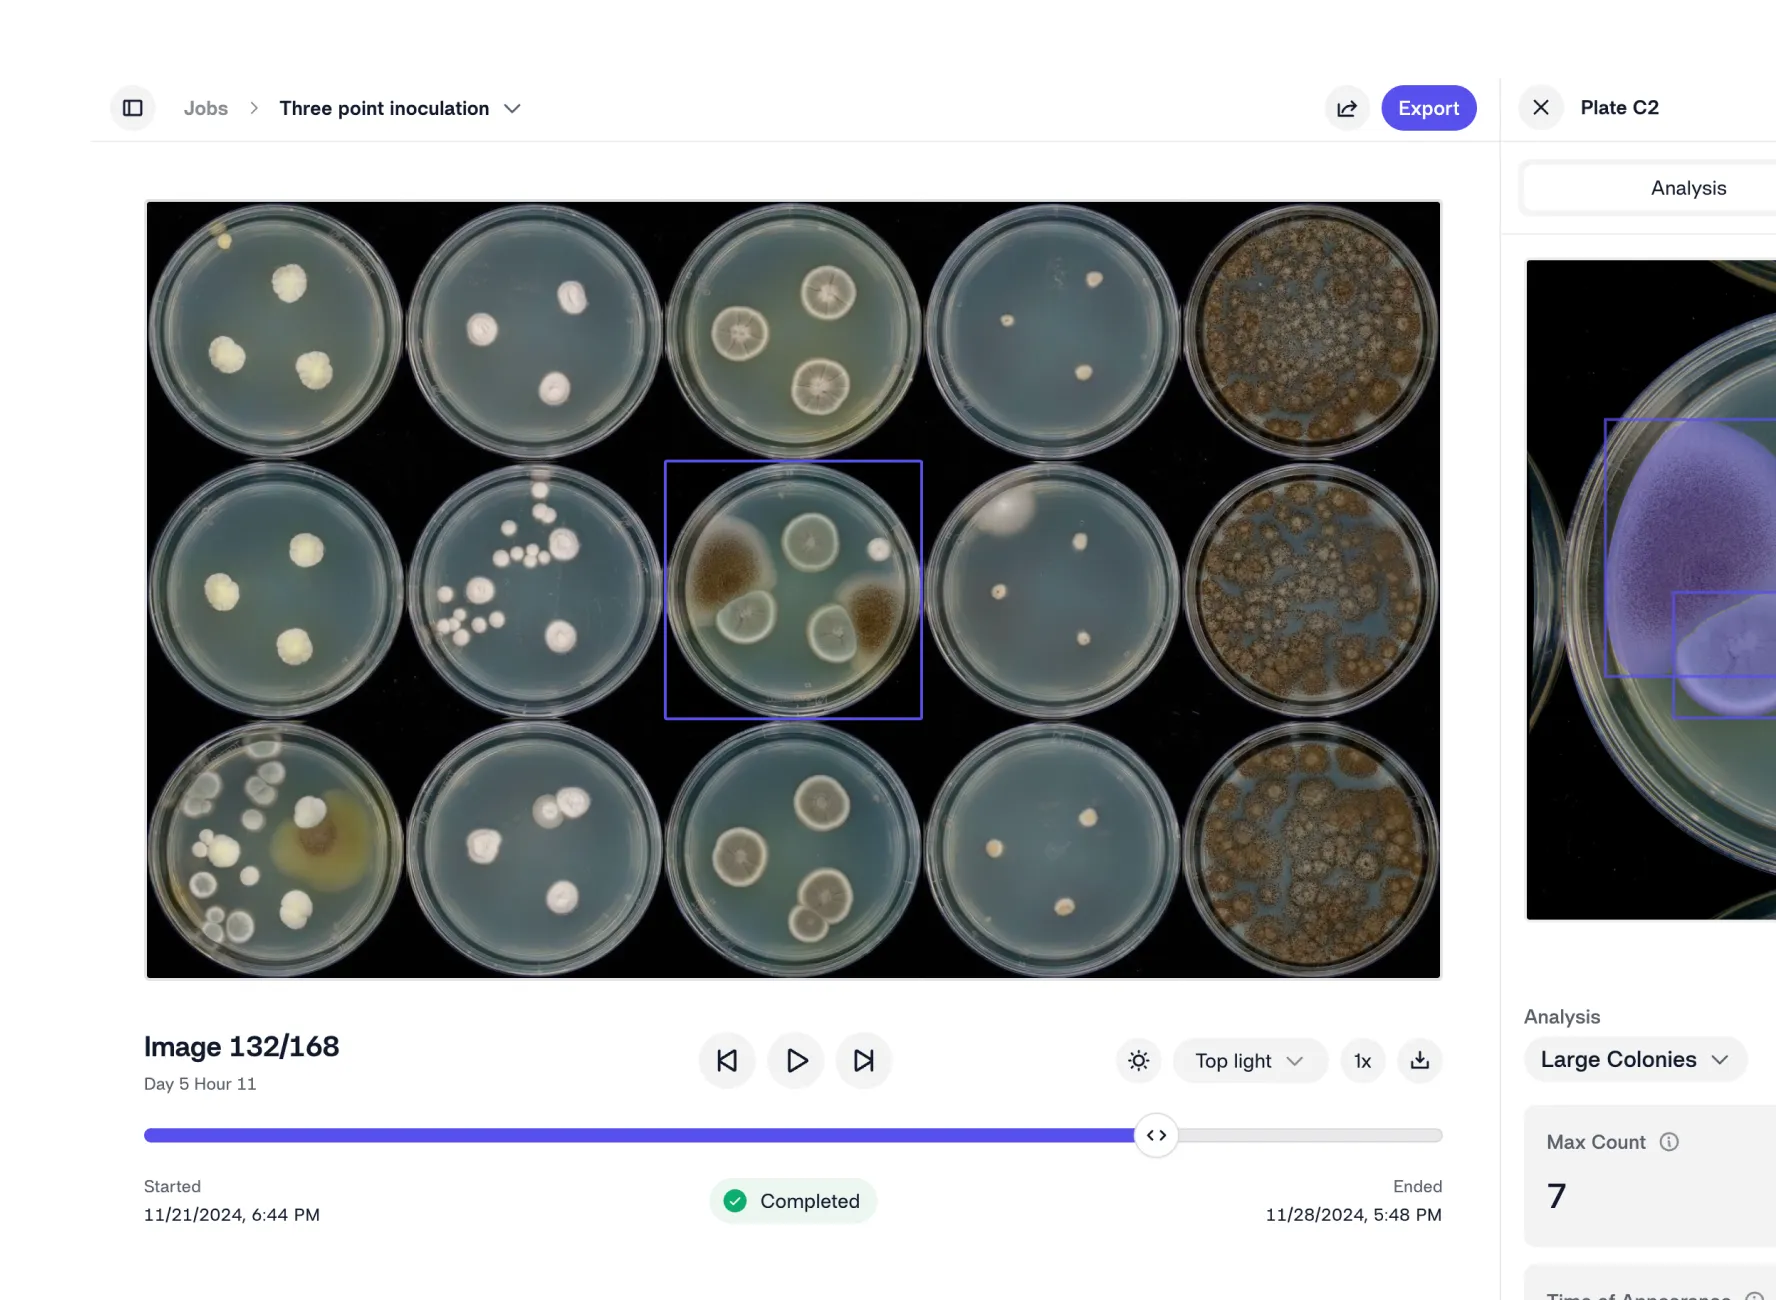

Control experiment parameters and produce objective, reliable and high-quality data that enables you to make decisions with confidence and clarity.
Standardize image input
Keep imaging conditions the same at all times. Capture single-point images or time-lapse images using three lighting presets.
Trust your data
Gain new levels of accuracy with analysis models continuously being trained on more than 40 million—and counting—images.

Always bias-free
Analysis models don’t get tired, don’t get influenced, and are immune to external circumstances. Your results are always 100% objective.

Documentation on autopilot
All results, metadata, and images are logged automatically. Get clean, structured documentation from day one without lifting a finger.
Move faster, minimize setbacks
Manual processes and messy data shouldn’t slow your team down. Reshape automates imaging and analysis so you can focus on what matters and keep your research moving forward.




Capture data 24/7
Don’t let office hours slow down your results. Automated image capture and analysis makes your pipeline work all day, every day.

Precision you can trust
High-resolution imaging and accurate, objective analysis give you consistent results you can rely on. Keep up your momentum without second-guessing.
Plates, trays, dishes – you name it
From petri dishes to omnitrays to microtiter plates – all the way down to 384 wells, we’re ready to handle whatever plate format you’re working with.

No more do-overs
Accurate, continuous data capture from the start helps you avoid wasted cycles and costly repeat experiments.
Fast-track discovery with AI-powered insights
Our smart analysis models automate data extraction and streamline how you conduct experiments, so your R&D team can move faster – and make smarter calls.
Reshape makes data management effortless—and keeps it compliant—with cloud access, powerful search, and real-time collaboration. Your team stays in sync, stays organized, and moves faster.

Everything in one place
All your research—past and present—lives in the cloud, searchable, sortable, and always accessible without needing to be on-site.

Teamwork without borders
Share and access data across teams with full scientific context. Less back-and-forth, no time zone barriers—just faster decisions.

Context is everything
Sync and edit experimental metadata right alongside your images and analysis, so you and your team always have the bigger picture and full context.

Stay compliant
Every change you make is tracked with a complete audit trail, keeping you fully aligned with internal standards and external regulations.




Reshape API
Sync your experiment designs directly to Reshape and watch everything come together as your data rolls in. Images and analysis stay tied to your original plan and results sync back to your data management system automatically. No gaps, no guesswork.
Learn more
Catch what you can’t see
With continuous high-res imaging and precise analysis, Reshape lets you capture what the human eye might miss and enables you to dig deeper into your data.
“With the help of Reshape, we have moved further in improving the workflow in 6 months than in the 3 years before with other solutions we tried.”
“Getting deep insights into everything that happens during our experiment is hugely helpful to discover new phenomena more quickly.”
"The Reshape system has revolutionized how we screen and study microbial clones. We can now track metabolite production, release, and diffusion at an unprecedented scale.”









